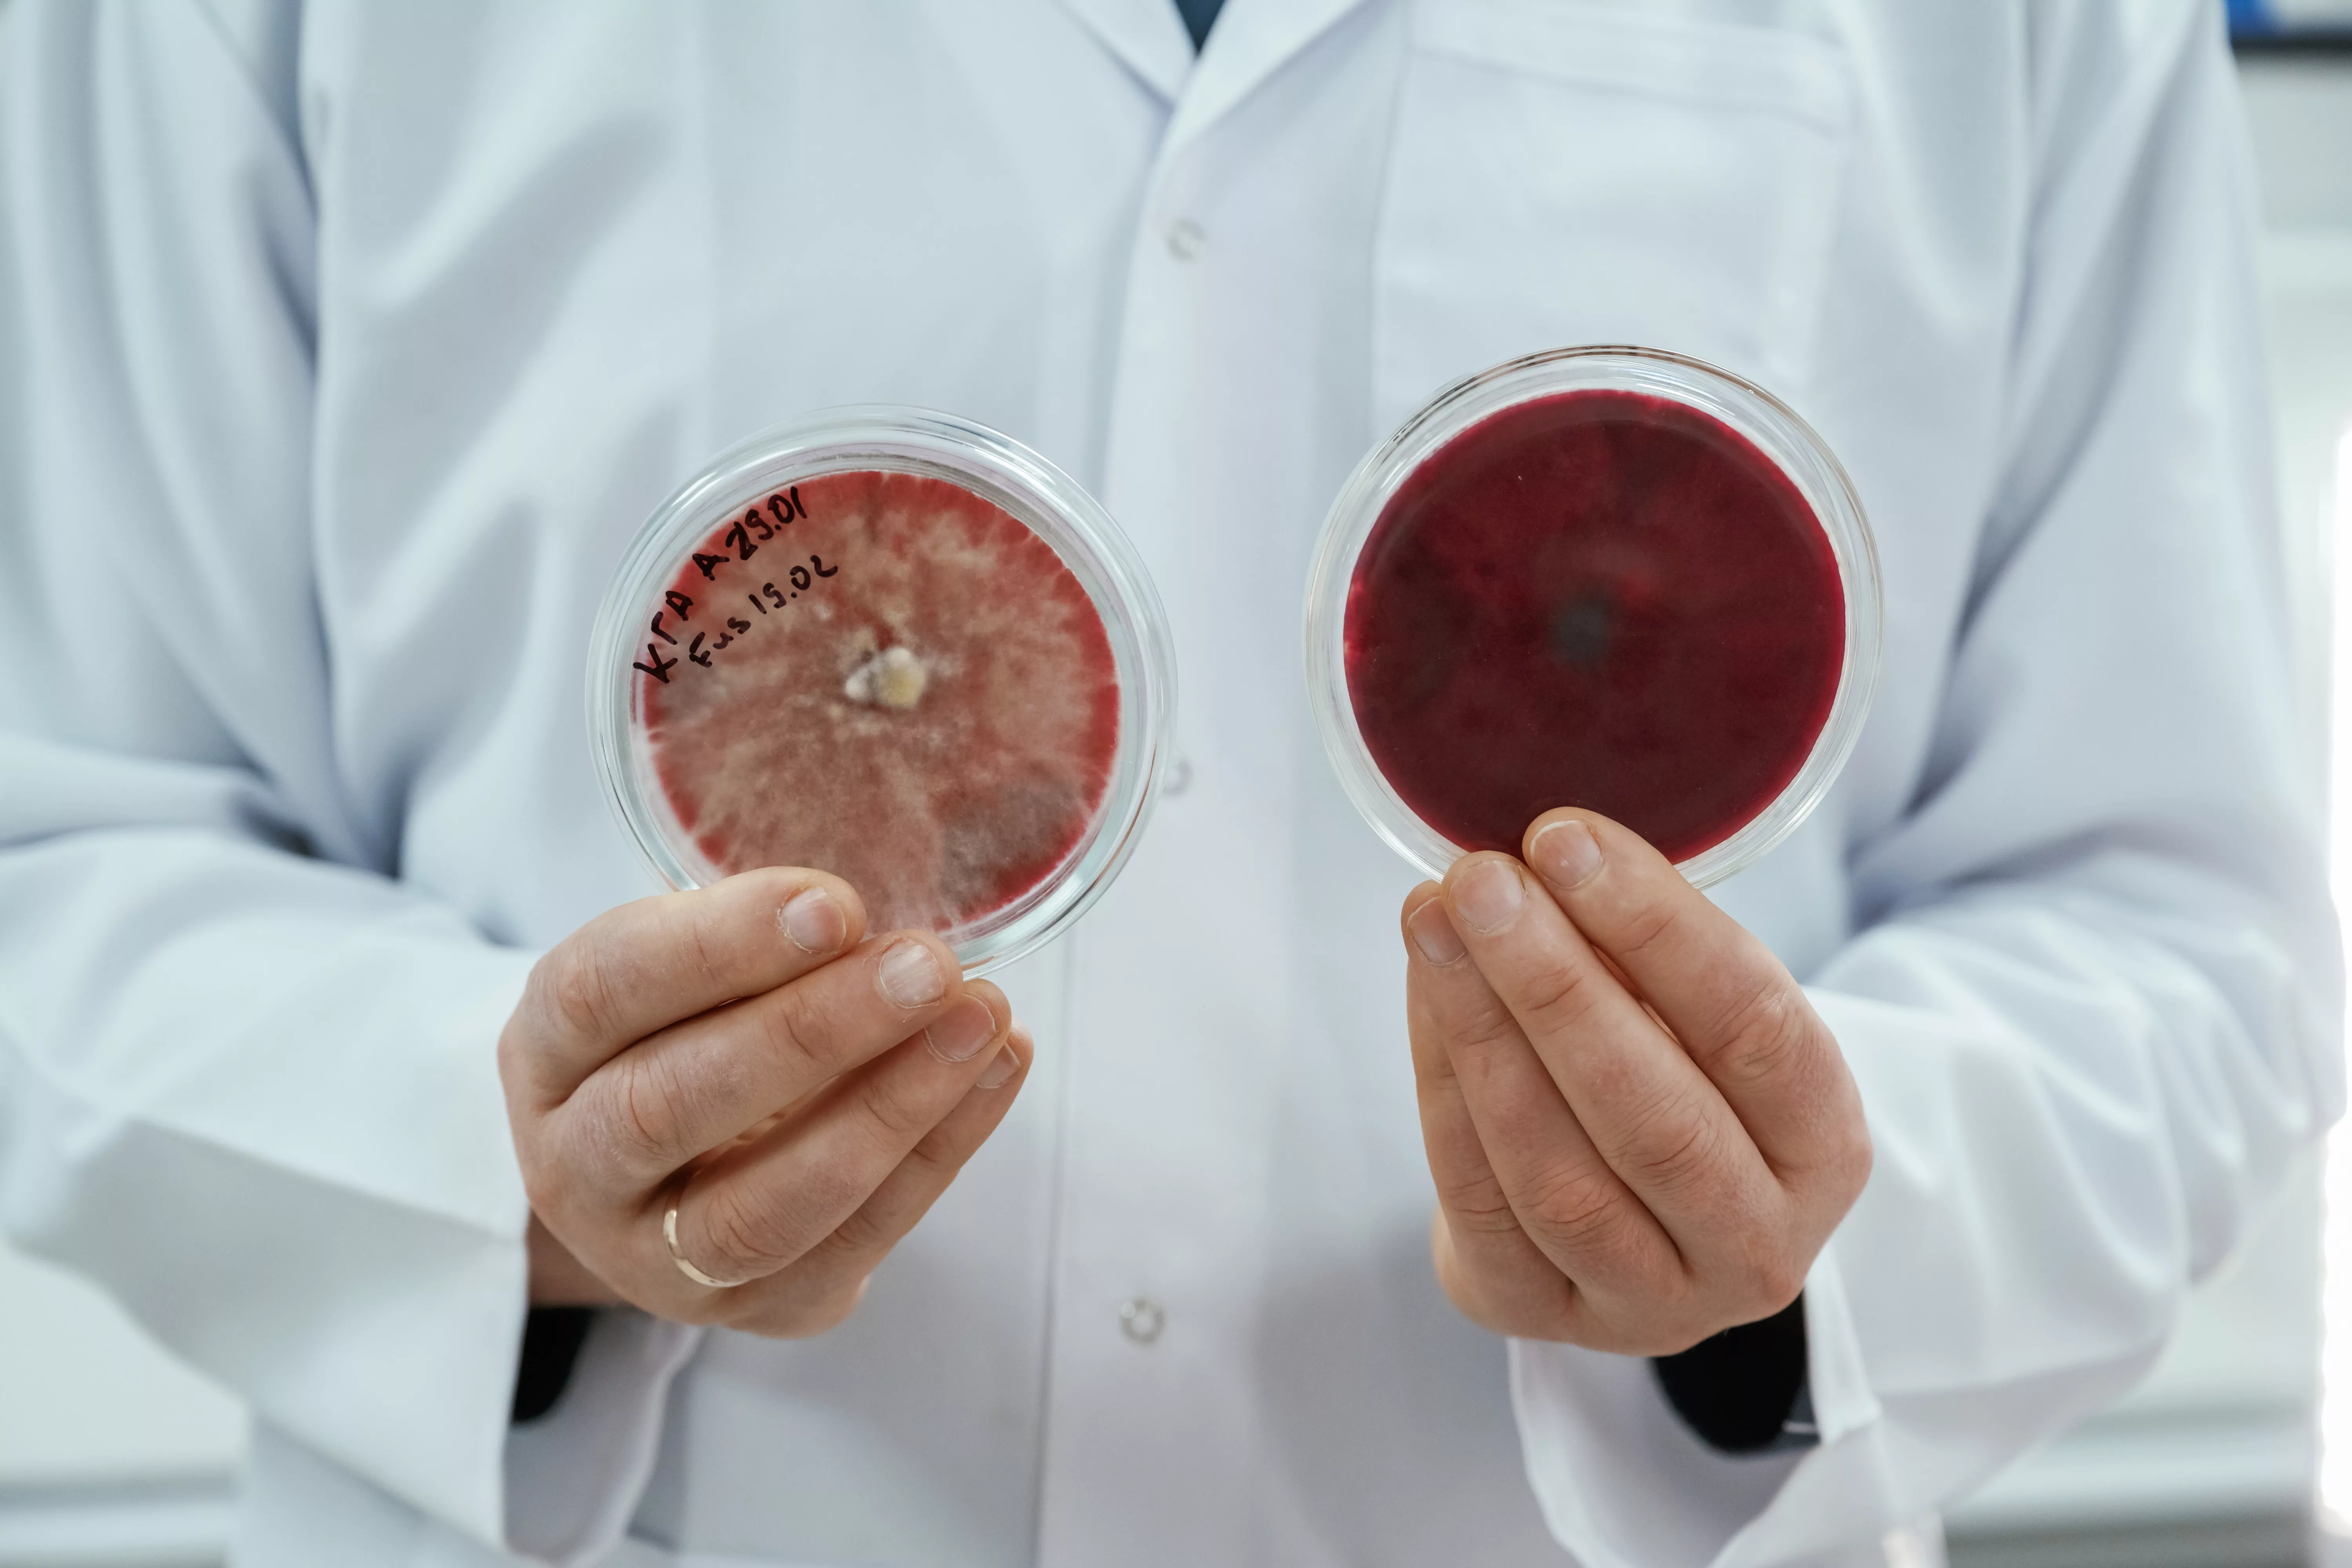
lab-worker-is-holding-containers-with-trichoderma-and-sclerotinia

Scientist holds two petri dishes of trichoderma and sclerotinia. Credit: Envato
By Stefan J. Bos, Chief International Correspondent Worthy News
NEW YORK (Worthy News) – “Superbugs,” the strains of bacteria resistant to several antibiotics, could cause more than 39 million deaths by 2050, a new study shows.
Some 70 percent of these deaths likely result from infections resistant to medications that could have treated them, warned the study published by the The Lancet, a leading weekly medical journal and one of the oldest of its kind.
Besides the nearly 40 million deaths directly linked to “superbugs,” the study also predicts that drug-resistant infections will play a role in 169 million deaths over the next 25 years.
The World Health Organization (WHO) has called antimicrobial resistance (AMR) “one of the top global public health and development threats.”
The WHO links these threats to “the misuse and overuse” of antimicrobial medications in humans, animals, and plants, which may help pathogens develop a resistance to them.
The researchers base their forecasts on analysis of recent deaths and the impact of measures to curb AMR deaths over time.
DRUG-RESISTANT
They found that more than 1 million people died each year as a result of drug-resistant infections between 1990 and 2021, a figure that is expected to increase over the following years.
The Global Research on Antimicrobial Resistance (GRAM) Project, which carried out the study, saw over 500 researchers collect and analyze data from 204 counties over 30 years in the first global analysis of AMR trends.
Based on that data, the researchers forecast that South Asia, Latin America, and the Caribbean will have the highest AMR mortality rates by 2050.
However, the GRAM study found that millions of deaths could be averted through better infection prevention, improved healthcare access, and new antibiotics.
The WHO says the main drivers of AMR are the overuse and misuse of antimicrobials.
The study’s results come ahead of a United Nations high-level meeting on AMR, which will convene in New York City on September 24, when medics are expected to focus on preventing more “superbugs” deaths.
The post ‘Superbugs To Kill Nearly 40 Million By 2050’, Study Warns appeared first on Worthy Christian News.








